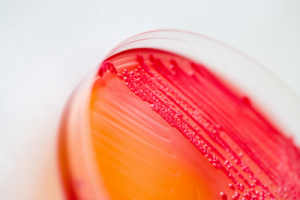
Culture Media

Contact us

GENERAL MICROBIOLOGY
Pioneering microbiology since 1902
With over a century of microbiology expertise, SSI Diagnostica Group is a trusted partner for clinical microbiological laboratories.
We offer a wide range of high-quality products, including antisera, ready-to-use media for diverse laboratory applications, and animal blood products sourced from our own horses, cattle, rabbits, and sheep.
Enabled by state-of-the-art production facilities and ISO 13485 certification, we specialize in large-scale production of culture media and reagents, delivering consistent quality and performance for laboratories worldwide.
Culture media
We produce a broad variety of culturing media, from solid agar plates to liquids in tubes. The products are all of high quality and made with care and precision.

Flexicult®
Flexicult® is your aid in diagnosis and treatment of urinary tract infections.

Animal blood products
Blood from horses, cattle and sheep can be delivered in a variety of volumes and stabilized by defibrination or by adding anticoagulants.

Sampling equipment
Sampling equipment is used for the collection, transport and storage of specimens from the collection point to examination in the laboratory. Choosing the right sampling equipment is crucial for qualified diagnostics.

Dermatophyte and C. Albicans real-time PCR kit
Our Dermatophyte RT-PCR kit has been upgraded. It now also detects C. albicans. Moreover, the sample material can be nail, skin, and hair.

Indicators
We are dedicated to deliver products that meet the highest standards of safety, reliability, and professional performance.
Trade products

Copan Swab & Media
Find sampling equipment from Copan

Copan WASP®
WASPLab® by COPAN is the fully automated solution for the multifunctioning microbiology lab.
Microbiologics
Find products from Microbiologics. Coming soon!

QuantiFERON®
Find IGRA tests from QuantiFERON®

Bio-Gram
Bio-Gram is a pioneer of alcohol-free staining solutions and staining systems. Their focus is on automatic and manual smear staining and sample preparation.

E&O Laboratories
Find products from E&O Laboratories.
HiMedia
Find products from HiMedia. Coming soon!

Liofilchem
Find products from Liofilchem.
Get in touch
If you have any questions, comments, or collaboration inquiries, you are very welcome to reach out.
Please fill in the form and we will get back to you as soon as possible.
Simpler for the better
If you work within the field of microbiology, you might be familiar with Occam’s Razor. At SSI Diagnostica, we champion a slightly adapted version of this principle:The simplest solution is usually the best one.